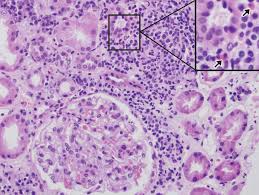

Akut Tübülointerstisyel Nefrit (TİN) Nedir?
Akut Tübülointerstisyel Nefrit (TİN) nedir? En sık nedeni olan ilaçlar, böbrek hasarı belirtileri ve kortizon ile uygulanan tedavi yöntemleri hakkında bilgi edinin.
Akut Tübülointerstisyel Nefrit (TİN), böbreklerin tübül adı verilen yapıları ve bu yapıları çevreleyen doku (interstisyum) bölgesinde hızla gelişen iltihaplanma ve ödem ile karakterize bir durumdur. Bu iltihap, genellikle akut böbrek yetmezliğine yol açarak böbrek fonksiyonlarında ani bozulmaya neden olur.
Nedenleri
TİN’in en sık nedeni bazı ilaçların kullanımıdır ve vakaların yaklaşık %60-70’inden sorumludur. Bu durum, genellikle ilaca karşı gelişen bir aşırı duyarlılık (alerjik reaksiyon) sonucu ortaya çıkar.
İlaçlar:
- Antibiyotikler (Penisilinler, Sülfonamidler, Sefalosporinler, Florokinolonlar vb.)
- Nonsteroid Antiinflamatuar İlaçlar (NSAİİ)
- Proton Pompa İnhibitörleri (PPİ)
- Diğer ilaçlar (Allopurinol, Diüretikler vb.)
- Enfeksiyonlar, bakteriyel (Pyelonefrit), viral (Hepatit B ve C, CMV, HIV) veya diğer enfeksiyonlar.
- Sistemik/otoimmün hastalıklar, sistemik Lupus Eritematozus (SLE), Sarkoidoz, Sjögren sendromu gibi hastalıklar.
Belirtileri ve Tanı
Belirtiler sıklıkla özgül değildir (spesifik değildir) ve bazı hastalarda sadece akut böbrek yetmezliği bulguları görülür. Ancak ilaçlara bağlı gelişen TİN’de bazen alerjik reaksiyon üçlüsü olarak bilinen belirtiler ortaya çıkabilir:
- Akut Böbrek Yetmezliği (Bulantı, kusma, halsizlik)
- Ateş
- Deri döküntüsü
- Eozinofili (Kanda bir beyaz kan hücresi türünün artması)
- Tanı için kesin yöntem, böbrek dokusundan parça alınmasıdır (böbrek biyopsisi).
Tedavi
- Sorumlu İlacın Kesilmesi: Eğer neden bir ilaç ise, ilacın hemen bırakılması tedavideki en kritik adımdır.
- İmmünsüpresif Tedavi: İlaç kesilmesine rağmen böbrek fonksiyonlarında düzelme olmazsa, genellikle iltihabı baskılamak için kortikosteroidler (Kortizon) gibi ilaçlar kullanılır.
- Destekleyici Tedavi: Akut böbrek yetmezliği tablosunu yönetmek için, bazen geçici olarak diyaliz tedavisi gerekebilir.
Kaynak
- İlaç İlişkili Akut İntertisyel Nefrit (JournalAgent) https://jag.journalagent.com/sislietfaltip/pdfs/SETB_50_4_251_255.pdf
- Akut İnterstisyel Nefrit – Acute Interstitial Nephritis (Turkish Journal of Nephrology) https://turkjnephrol.org/Content/files/sayilar/360/38-42(1).pdf
- İntersitisyel Nefrit (Vikipedi) https://tr.wikipedia.org/wiki/%C4%B0ntersitisyel_nefrit
- İnterstisyel Nefritler/ Tubulointerstisyel Nefrit (TİN) (Prof. Dr. Aydın ECE) https://www.aydinece.com/upload/tubulointerstisyel-nefrit-96380.pdf
- Nefrit Nedir? Tedavisi ve Belirtileri (Prof. Dr. Murat ARSLAN) https://www.drmuratarslan.com/nefrit/